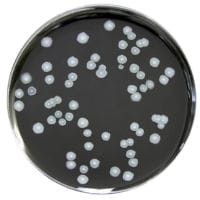
Legionella BCYE Medium gotowa pożywka do oznaczania bakterii z rodzaju Legionella

Znaleziono produktów: 287
Haemophilus Selective Agar gotowa pożywka na płytkach do izolacji gatunków Haemophilus

• Opakowanie: 10 szt.
• Płytka: 90 mm.
• Do izolacji gatunków Haemophilus
• Wyrób medyczny: Tak.
Hektoen Enteric Agar gotowa pożywka na płytkach do izolacji Shigella i Salmonella spp.

• Opakowanie: 10 szt.
• Płytka: 90 mm.
• Do izolacji Shigella i Salmonella spp.
• Wyrób medyczny: Tak
Kanamycin Aesculin Azide Selective Medium gotowa pożywka na płytkach do oznaczania enterokoków z próbek żywności

• Opakowanie: 10 szt.
• Płytka: 90 mm.
• Do oznaczania enterokoków z próbek żywności
Legionella BCYE Medium gotowa pożywka do oznaczania bakterii z rodzaju Legionella
•Opakowanie: 10 szt.
•Płytki: 90 mm.
•Wyrób medyczny: Tak
Legionella BCYE with Antibiotics gotowa pożywka na płytkach do izolowania Legionellaceae

• Opakowanie: 10 szt.
• Płytka: 90 mm.
• Do izolowania Legionellaceae.
Legionella BCYEa Medium bez cysteiny gotowa pożywka na płytkach

• Opakowanie: 10 szt.
• Wyrób medyczny: Tak
Legionella GVPC Selective Medium gotowa pożywka

Gotowe podłoże GVPC
• Płytki: 90 mm.
• Opakowanie: 10 szt.
M.R.S. Agar gotowa pożywka na płytkach do oznaczania kwasu mlekowego

• Opakowanie: 10 szt.
• Płytka: 90 mm
• Wyrób medyczny: Tak
MacConkey Agar No. 3 gotowa pożywka na płytkach do wykrywania E. coli

• Opakowanie: 10 szt.
• Płytka: 90 mm.
• Wyrób medyczny: Tak
Mannitol Salt Agar gotowa pożywka do oznaczania gronkowców

• Opakowanie: 10 szt.
• Płytka: 90 mm.
• Wyrób medyczny: Tak
Maximum Recovery Diluent gotowa pożywka w probówkach

• Opakowanie: 50 x 9 ml.
• Gotowa pożywka w próbkach.
• Wyrób medyczny: Tak.
Maximum Recovery Diluent pożywka sypka 500g

Buforowana woda peptonowa (odwodniona)
• Postać - Proszek 500g
• Wydajność 52.6 l
darmowa i wygodna wysyłka
już od 800 zł netto
Najwyższa jakość
produktów potwierdzona certyfikatami
Zakupy 24h na dobę
wygodne i bezpieczne
bezpłatna konsultacja
z ekspertem online

